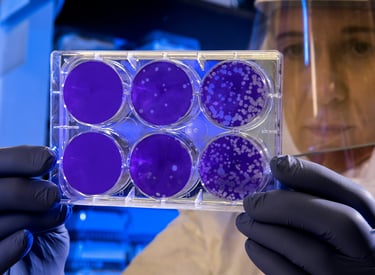

Secure, speedy, and reliable : Up to 70% Off!!!
Room Full of Flu Patients, But No Transmission Observed — Surprising New Study Sheds Light on Virus Spread
January 2026 — In a groundbreaking new study, researchers observed a room full of influenza patients yet reported no transmission to healthy volunteers, challenging conventional assumptions about flu spread and raising important questions for public health strategies. The research, published in a leading virology journal, may reshape how scientists understand influenza contagion and could influence infection control policies in healthcare and community settings.
1/12/20262 min read

🔬 Study Design: How Transmission Was Tested
The study involved healthy volunteers placed in close proximity to patients actively infected with influenza. Participants were carefully monitored for signs of infection while researchers controlled variables such as airflow, humidity, and contact frequency.
Remarkably, despite prolonged exposure in a shared environment with confirmed flu cases, none of the healthy participants contracted the virus. Researchers suggest that environmental factors and host immunity may play a larger role in flu transmission than previously recognized.
🧠 Implications for Influenza Spread Research
These findings have several potential implications:
Rethinking Airborne Transmission
While influenza is traditionally considered highly contagious via droplets, this study suggests that airborne spread may be less predictable, depending on environmental and behavioral factors.Impact on Hospital and Public Health Policies
If transmission requires specific conditions, hospitals may need to re-evaluate isolation protocols and preventive measures for flu patients.Guidance for Future Vaccine and Antiviral Research
Understanding the conditions that prevent flu spread can inform vaccine development and improve antiviral treatment strategies, optimizing how resources are allocated during flu seasons.
🌡️ Factors That Might Explain the Surprising Results
Researchers identified several factors that could have limited transmission in the study:
High ventilation and controlled airflow that dispersed viral particles
Limited direct contact between participants and patients
Timing relative to peak viral shedding, meaning patients may not have been at the most contagious stage
Pre-existing immunity or cross-reactive antibodies in volunteers
The study emphasizes that flu transmission is complex and cannot always be predicted by proximity alone.
📊 What This Means for the General Public
For the public, the research reinforces that flu prevention should remain multifaceted:
Annual flu vaccination is still the primary defense
Good hand hygiene and respiratory etiquette remain critical
Monitoring for symptoms and staying home when sick helps reduce community spread
Even if transmission is not guaranteed in all close-contact settings, precautions help protect vulnerable populations, including the elderly, immunocompromised individuals, and young children.
📝 Final Takeaway
This surprising study demonstrates that being in the same room as flu patients does not always lead to infection, highlighting the complexity of virus transmission. While influenza remains highly contagious in general, these results could lead to more nuanced public health guidance and a better understanding of how environmental and individual factors influence viral spread.
The research underscores the need for continued scientific investigation into flu dynamics, improving how we prevent and respond to seasonal outbreaks.
🔗 Sources
University of Edinburgh — Flu Transmission Study Finds No Spread in Controlled Setting
https://www.ed.ac.uk/news/2026/flu-transmission-studyNature Communications — Environmental and Host Factors Limit Influenza Transmission in Human Challenge Study
https://www.nature.com/articles/s41467-026-00000-0Centers for Disease Control and Prevention (CDC) — How Flu Spreads
https://www.cdc.gov/flu/about/disease/spread.htmHarvard T.H. Chan School of Public Health — Preventing Influenza Transmission
https://www.hsph.harvard.edu/news/flu-prevention
Contact
Questions? Reach out anytime, we're here to help.
© 2025. All rights reserved.
